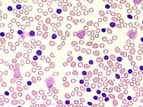

Kurzbeschreibung:
Die CLL macht 25% aller Leukämien aus. Sie gehört zum Formenkreis der lymphoproliferativen Syndrome. Die CLL tritt fast ausschliesslich im höheren Alter auf und kommt fast nie unter 40 vor. Oft wird die Diagnose zufällig im Blutbild festgestellt und zum entsprechenden Zeitpunkt bestehen noch keine Beschwerden. Der Verlauf ist langsam progredient und eine Therapie wird nur beim Auftreten von Beschwerden durchgeführt.
Klinisches Bild:
Die Krankheit bleibt lange asymptomatisch. Symmetrische Lymphknotenschwellungen und Splenomegalie sind häufig. Der Grad der Anämie und Thrombozytopenie ist von zentraler prognostischer Bedeutung. Nach Jahren kommt es durch Knochenmarkinfiltration zum Zusammenbruch der Hämopoiese, der dann zum Exitus führt. Die Therapie, meist mit alkylierenden Substanzen, führt in der Frühphase meist zu einem raschen Rückgang der Beschwerden. Die Therapie hat aber keinen eindeutigen Einfluss auf den Verlauf. Eine Hypogammaglobulinämie führt zu vermehrten respiratorischen Infekten. In rund 10% der Fälle tritt im Verlauf eine Autoimmunhämolyse auf.
Hämatologie:
 Zur CLL gehört eine persistierende Erhöhung reifer, kleiner B-Lymphozyten über 10x109/L. Die Lymphozytenzahl kann Werte bis zu 150x109/L und mehr erreichen. Lädierte Lymphozyten im Blutausstrich, sogenannte Gumprecht'sche Schollen, sind typisch für die CLL. Anämie und Thrombozytopenie sind Zeichen zunehmender Knochenmarkinfiltration.
Zur CLL gehört eine persistierende Erhöhung reifer, kleiner B-Lymphozyten über 10x109/L. Die Lymphozytenzahl kann Werte bis zu 150x109/L und mehr erreichen. Lädierte Lymphozyten im Blutausstrich, sogenannte Gumprecht'sche Schollen, sind typisch für die CLL. Anämie und Thrombozytopenie sind Zeichen zunehmender Knochenmarkinfiltration.
Knochenmark:
 Im Knochenmark besteht eine Infiltration durch kleine Lymphozyten von über 40%. Die normale Hämatopoiese ist mehr oder weniger verdrängt.
Im Knochenmark besteht eine Infiltration durch kleine Lymphozyten von über 40%. Die normale Hämatopoiese ist mehr oder weniger verdrängt.
Inhaltsverzeichnis
Zur CLL gehört eine persistierende Erhöhung reifer, kleiner B-Lymphozyten über 10x109/L. Die Lymphozytenzahl kann Werte bis zu 150x109/L und mehr erreichen. Lädierte Lymphozyten im Blutausstrich, sogenannte Gumprecht'sche Schollen, sind typisch für die CLL. Anämie und Thrombozytopenie sind Zeichen zunehmender Knochenmarkinfiltration.
Zur CLL gehört eine persistierende Erhöhung reifer, kleiner B-Lymphozyten über 10x109/L. Die Lymphozytenzahl kann Werte bis zu 150x109/L und mehr erreichen. Lädierte Lymphozyten im Blutausstrich, sogenannte Gumprecht'sche Schollen, sind typisch für die CLL. Anämie und Thrombozytopenie sind Zeichen zunehmender Knochenmarkinfiltration. Im Knochenmark besteht eine Infiltration durch kleine Lymphozyten von über 40%. Die normale Hämatopoiese ist mehr oder weniger verdrängt.
Im Knochenmark besteht eine Infiltration durch kleine Lymphozyten von über 40%. Die normale Hämatopoiese ist mehr oder weniger verdrängt.